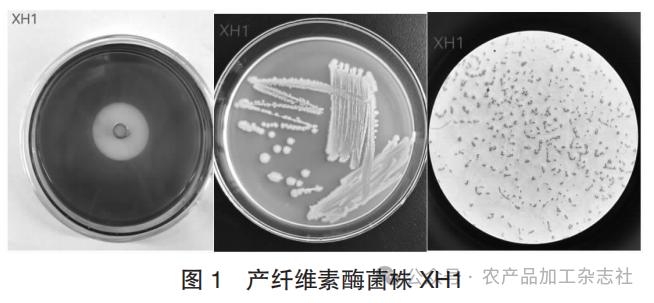
图 1 产纤维素酶菌株 XH1.png

论文推荐│香菇废菌棒诱导黑水虻肠道纤维素降解菌筛选
香菇废菌棒诱导黑水虻肠道纤维素降解菌筛选
作 者
覃春桃,余洪勤,*王颖娟
作者单位
兴义民族师范学院 民族药用生物资源研究与开发实验室
引用格式
覃春桃,余洪勤,王颖娟.香菇废菌棒诱导黑水虻肠道纤维素降解菌筛选[J].农产品加工,2025,(01):68-70.
基金项目
摘 要
通过用香菇废菌棒饲养黑水虻,诱导建立肠道菌群,利用羧甲基纤维素钠培养基和卢戈氏碘液染色法,分离筛选肠道高产纤维素酶菌株并测定滤纸酶活力。结果表明,从香菇废菌棒诱导黑水虻肠道菌群中,筛选出1株高产纤维素酶分解菌,其D/d值达4.17,滤纸酶活力为100.43 U/mL,显示具有较高的纤维素降解能力。
关 键 词
纤维素;纤维素酶;纤维素降解菌;筛选;黑水虻
正 文
香菇以其营养成分丰富、药用保健价值高等优点而深受人们喜爱[1]。我国是香菇生产大国,随着其规模化生产,产生了数量巨大的香菇废菌棒。香菇废菌棒中含有大量的纤维素、木质素、半纤维素,未能合理利用,造成资源的浪费[2-5]。在自然界中,许多昆虫能以木质纤维素为食,降解腐殖质中的有机物,主要是因为其肠道中共存有能协助昆虫消化吸收食物中木质素和纤维素等难降解物质的微生物[6],已有报道从白蚁、天牛、金龟、蝗虫等昆虫体内分离到产纤维素酶菌株[7-15]。黑水虻(Hermetia illucens)为双翅目水虻科扁角水虻属的一种,其幼虫可以取食多种有机废物,已经被广泛地应用于有机废弃物的生物转化过程中[16-17]。用香菇废菌棒饲养黑水虻虫,促进黑水虻幼虫建立肠道菌群,分离筛选黑水虻幼虫肠道内的纤维素降解菌,为提高香菇废菌棒的生物转化提供参考依据。
1 材料与方法
1.1 试验材料
香菇废菌棒,贵州福顺三友农业生物科技有限公司提供。晒干后用粉碎机粉碎,过40目筛,备用。
黑水虻(陈记虻虫卵),虫卵在温度30 ℃,湿度80%左右的麦麸中饲养至四龄,备用。称取10 g黑水虻幼虫与20 g废菌棒,加水使废菌棒的含水量为70%,按1∶2的虫料比置于饲养盒中,并置于25 ℃恒温培养箱中饲养30 d,分离出黑水虻,基质烘干(基质与昆虫排泄物无法分离),粉碎,过60目筛,备用。
1.2 培养基及试剂
1)筛选培养基。CMC-Na /木质素磺酸钠1.5 g,蛋白胨5 g,氯化钠2.5 g,琼脂10 g,去离子水500 mL。
2)LB液体培养基。牛肉膏1.5 g,蛋白胨5 g,氯化钠2.5 g,去离子水500 mL。
3)产酶培养基。蛋白胨5 g,牛肉膏2.5 g,氯化钠2.5 g,CMC-Na /木质素磺酸钠2.5 g,去离子水500 mL。
番红、结晶紫染液,DNS溶液,pH值4.8柠檬酸缓冲液0.05 mol/L。
1.3 黑水虻对香菇废菌棒纤维素消化率
精准称取0.8 g过筛后的饲养前、后废菌棒于500 mL锥形瓶中,加入质量分数为72%的H2SO4溶液,摇匀后置于水浴锅中,在30 ℃下反应1 h,之后加入质量分数为4%的H2SO4溶液8 mL,水浴锅30 ℃下反应45 min,最后加入224 mL蒸馏水,摇匀,于121 ℃立式高压蒸汽灭菌锅中保温1 h,过滤得样品溶液,残渣及滤液备用。将滤液10倍稀释,取1 mL于试管中,加入1 mL蒽酮试剂,80%H2SO4溶液3 mL,混匀,在100 ℃下煮沸5 min,室温冷却。于波长620 nm处测定各滤液的吸光度,代入葡萄糖标准曲线回归方程:Y=3.517 4X+ 0.005 2(R2= 0.999 3),计算样品溶液的葡萄糖质量浓度。根据公式(1),计算饲养前、后菌棒中纤维素的含量。

式中:C——由标准曲线计算出的葡萄糖质量浓度,
mg/mL;
V——样品溶液总体积,mL;
R2——系数;
m——制备样品溶液时加入的样品质量,mg。
1.4 肠道分离及肠道菌悬液制备
取上述试验所得黑水虻30只,分别于超净工作台上用无菌水冲洗虫体,直至虫体表面冲洗干净,再用75%酒精消毒3 min,然后用无菌水清洗3次,将其移至已灭菌的培养皿中,用灭菌的剪刀从腹部侧面剪至头部,将虫体腹部拨开,取出肠道,放入无菌的研钵中研磨,加无菌水,制成肠道菌悬液。将全部菌悬液加入到LB 液体培养基进行细菌富集,在37 ℃下以转速150 r/min振荡培养24 h。
1.5 纤维素降解菌的分离纯化
将上述富集培养的菌液按10-4,10-5,10-6,10-7 倍梯度稀释,吸取100 μL稀释后的菌液于纤维素筛选培养基平板上,均匀涂布,置于37 ℃生化培养箱中倒置培养,待菌株长出后,根据菌落的形态、颜色及透明度的不同挑取单菌落,利用平板划线法进行分离纯化。待纯化4~5次后备用。
1.6 纤维素降解菌株筛选
将纯化好的菌株点接纤维素筛选培养基上,于37 ℃生化培养箱中倒置培养24 h。在纤维素筛选培养基中滴加适量卢戈氏碘液,使其覆盖住全部培养基,静置一段时间后,用去离子水清洗,观察培养基上的菌落是否出现透明圈。测量透明圈直径(D)及菌落直径(d)。取有透明圈的菌株纯化3次至纯菌落,接种到斜面培养基,在37 ℃下培养24 h 后,置于4 ℃下冷藏保菌。
1.7 纤维素降解菌株酶活测定
1.7.1 粗酶液制备
取4℃冷藏保存的菌株接种到LB液体培养基中,在37 ℃下以转速180 r/min在恒温摇床中振荡富集培养,待菌液的D600 nm达到1.0时,取1 mL富集培养菌液于产酶培养基中,在37 ℃下以转速180 r/min振荡培养24h后,以转速6 000 r/min离心10 min收集上清液,即为纤维素酶活测定的粗酶液。
1.7.2 酶活力标准曲线制备
配制质量浓度为0.1,0.2,0.3,0.4,0.5 mg/mL的葡萄糖标准溶液,取2 mL蒸馏水于空白试管,2 mL各质量浓度葡萄糖标准溶液于另5支试管中,再依次加入蒸馏水2 mL和DNS溶液5 mL,将上述溶液混合均匀后于沸水浴中煮沸5 min,冷却至室温后,用蒸馏水定容至25 mL,于波长540 nm处测定吸光度,以吸光度为纵坐标,葡萄糖质量浓度为横坐标,绘制标准曲线及回归方程。Y=0.956 6X-0.022 6(R2=0.992 3)。
1.7.3 滤纸酶活力(FPA)
将3.0 cm×3.0 cm的定性滤纸剪成碎片,置于试管中,加入上述粗酶液1 mL,浓度为0.05 mol/L柠檬酸缓冲液(pH值4.8)1.5 mL,混合均匀后置于50 ℃水浴锅中反应30 min,再加入2.5 mL DNS试剂并迅速摇匀,置于沸水浴中加热5 min,流水冷却后加去离子水定容至10 mL,倒入比色皿,于波长540 nm处测得吸光度。以蒸馏水为空白对照,每组设置3个平行试验。根据下列公式计算出酶活力。

式中:A——所测吸光度代入标准曲线得到的葡萄糖
含量,mg;
n——稀释倍数;
1 000——转化因子;
t——酶解反应时间,min;
V——粗酶液体积,mL。
2 结果与分析
2.1 黑水虻对香菇废菌棒纤维素的消化率
黑水虻在香菇废菌棒制成的基质中能够正常存活,通过测定饲喂前后香菇废菌棒中纤维素的含量。
黑水虻对香菇废菌棒纤维素消化率见表1。

结果显示,香菇废菌棒中纤维素含量在饲喂前后有较大下降,说明黑水虻对香菇废菌棒中纤维素有消化分解能力,消化率达23.21%。
2.2 产纤维素酶菌株分离筛选
通过对黑水虻幼虫肠道菌群进行纤维素筛选培养,并经卢戈氏碘液染色观测透明圈出现,筛选到1株纤维素降解菌,命名为XH1(见图1)。XH1菌落特征为菌落圆形,白色,有隆起,表明湿润,边缘完整,不透明。经革兰氏染色,为革兰氏阴性菌,有荚膜,杆状,单个、成对或成链状排列,可能为克雷伯氏菌属(Klebsiella)。
产纤维素酶菌株XH1见图1。
2.3 产纤维素酶菌酶活力测定
通过测量透明圈及菌落直径,计算透明圈与菌落直径的比值;FPA法测菌株降解纤维素酶活力值。结果表明,该株菌有明显的透明圈,D/d值达4.17,显示对纤维素具有降解能力。该菌株滤纸酶活力为100.43 U/mL。
高产纤维素酶菌株的酶活见表2。

3 结论
以香菇废菌棒为饲养基质诱导黑水虻幼虫肠道建立的菌群,再利用纤维素筛选培养基和卢戈氏碘液染色进行筛选,发现黑水虻幼虫肠道中存在着可降解香菇废菌棒中纤维素的菌群,分离纯化获得 1株纤维素降解菌,其D/d值达4.17,滤纸酶活力为100.43 U/mL,显示具有较高的纤维素降解能力。
香菇废菌棒中残余大量木质纤维素,是一种重要的可再生生物质能源,其有效利用一直是焦点的问题[1-2]。黑水虻是一种可高效生物转化有机废弃物的昆虫,其肠道中的共生菌群不仅对宿主正常的生命活动有重要作用,还是其无害化和资源化处理有机废弃物的关键[17]。分离并鉴定其中具有纤维素分解能力的菌株,筛选高产纤维素酶的菌株,对于木质纤维素的分解具有积极意义,为降解木质纤维素提供更多可选择的菌种,也为食用菌废菌棒的生物转化更多途径。
参考文献:
[1]李淼儿,唐金凤,王桂林,等. 香菇菌糠的研究进展 [J]. 广州化工,2023,51(14):16-18.
[2]秦翠兰,赵群喜,王磊元. 废弃菌棒生物质资源综合利用现状及其展望[J]. 新疆农机化, 2022(1):22-24,39.
[3]童晨晓,邹双全,胡坤,等. 废菌棒替代泥炭土对金线莲生长和品质的影响[J]. 江西农业大学学报,2020, 42(5):915-922.
[4]成群. 废菌棒再利用的技术探讨[J]. 陕西农业科学,2012,58(1):262-263.
[5]朱守亮,张绍刚,董晓庆. 贵州省食用菌废菌棒处理和再利用浅谈[J]. 耕作与栽培,2017(1):45-47.
[6]姜义仁,王志强,王楠,等. 中国资源昆虫产业发展趋势研究[J]. 沈阳农业大学学报(社会科学版),2017, 19(5):542-548.
[7]徐荣. 木食性高等白蚁肠道内纤维素降解菌的筛选及酶活性分析[D]. 武汉:华中师范大学,2015.
[8]高云航,王巍,刘萌,等. 白蚁肠道木质素分解菌、染料脱色菌的分离鉴定及产酶条件优化[J]. 上海交通大学学报(农业科学版),2014,32(5):12-19.
[9]王建梅. 3种蝗虫的肠道微生物多样性分析及纤维素降解菌的分离[D]. 保定:河北大学,2020.
[10]刘晨娟,蔡皓,李庆,等. 桑粒肩天牛肠道木质纤维素分解细菌的分离和鉴定[J]. 化学与生物工程,2010, 27(7):66-68,91.
[11]罗巧玉. 松墨天牛幼虫肠道细菌多样性及纤维素降解功能研究[D]. 福州:福建农林大学,2022.
[12]高云航,王巍,李秋菊,等. 白蚁肠道木质素及纤维素分解菌的分离鉴定及产酶条件优化[J]. 中山大学学报(自然科学版),2013,52(2):84-89.
[13]黄婉秋. 白星花金龟幼虫肠道中纤维素降解菌的筛选及其作用[D]. 北京:中国农业科学院,2021.
[14]黄婉秋,石冬冬,蔡红英,等. 白星花金龟幼虫肠道中纤维素降解菌的筛选及其全基因组分析[J]. 中国农业科技导报,2021,23(6):51-58.
[15]白竞. 5种蝗虫肠道微生物多样性分析及纤维素分解菌的分离鉴定[D]. 保定:河北大学,2021.
[16]杜娟. 资源昆虫黑水虻的利用与开发探讨[J]. 现代农业科技,2020(12):221-222.
[17]刘存成. 黑水虻转化降解抗生素的微生物生态机制[D].武汉:武汉工程大学,2022. ◇